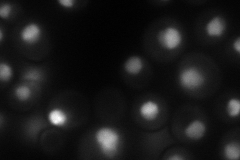
YGL122C
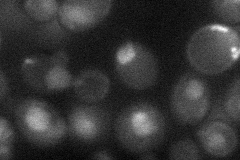
YGL122C
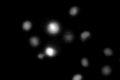
YGL122C

View description
Nuclear polyadenylated RNA-binding protein required for nuclear mRNA export and poly(A) tail length control; binds nuclear pore protein Mlp1p; autoregulates mRNA levels; related to human hnRNPs; nuclear localization sequence binds Kap104p
Localization:
Intensity:
Fold change:
Significance:
-
C’ GFP library in SD

nucleus163.51 -
N' NOP1pr-GFP in SD
nucleus,nucleolus86.6471 -
N' TEF2pr-mCherry in SD

nucleus,nucleolus16.4405 -
N' NATIVEpr-GFP in SD

nucleus117.276 -
N' TEF2pr-VC and Cyto-VN in SD
cytosol31.3815 -
C’ GFP library in SD+DTT

nucleus209.231.27No -
C’ GFP library in SD+H2O2
nucleus171.531.04No -
C’ GFP library in Starvation Media

nucleus137.80.84No -
C’ GFP library on the background of Pup2-DaMP

nucleus -
C’ GFP library on the background of CCT mutant

nucleus171.5371.04906No
